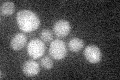
YOR349W
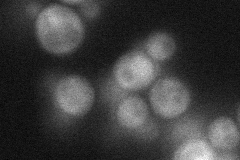
YOR349W
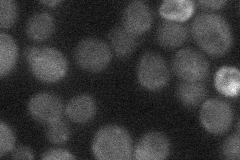
YOR349W
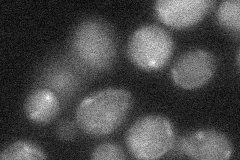
YOR349W

View description
Tubulin folding factor D involved in beta-tubulin (Tub2p) folding; isolated as mutant with increased chromosome loss and sensitivity to benomyl
Localization:
Intensity:
Fold change:
Significance:
-
C’ GFP library in SD
below threshold18.51 -
N' NOP1pr-GFP in SD
cytosol28.3419 -
N' TEF2pr-mCherry in SD

below threshold10.8119 -
N' NATIVEpr-GFP in SD
below threshold22.8616 -
N' TEF2pr-VC and Cyto-VN in SD
below threshold25.181 -
C’ GFP library in SD+DTT

cytosol17.10.92No -
C’ GFP library in SD+H2O2

cytosol21.421.15No -
C’ GFP library in Starvation Media

cytosol18.270.98No -
C’ GFP library on the background of Pup2-DaMP

below threshold -
C’ GFP library on the background of CCT mutant

below threshold22.8971.23643No
